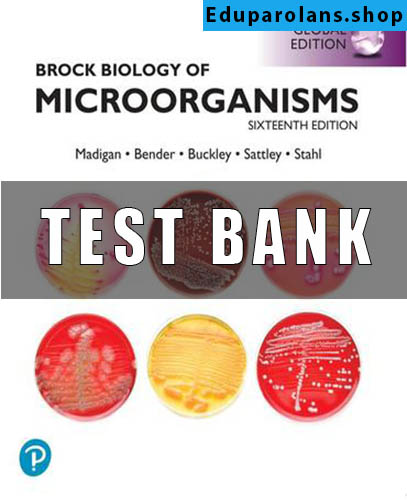

Test Bank for Brock Biology of Microorganisms, 16th Global Edition
Looking for comprehensive resources to ace your nursing exams, banking exams, SATs, or any other test? Look no further! Our extensive collection of test banks is designed to help you succeed in your academic and professional pursuits.
Whether you’re a nursing student preparing for your exams or a banking professional aiming to excel in banking exams, our test bank is a valuable tool to enhance your knowledge and boost your confidence. Packed with a wide range of test bank questions, including those focusing on nursing, pharmacology, medical-surgical concepts, and more, our test bank offers a diverse array of practice materials to suit your specific needs.
With our test bank, you can access a wealth of test bank questions and answers, providing you with ample opportunities to practice and reinforce your understanding of key topics. We understand that thorough preparation is crucial for success, which is why our test bank is meticulously curated to cover a comprehensive range of subjects and ensure you are well-prepared for any test or exam.
Whether you’re studying independently or as part of a structured curriculum, our test bank is a trusted resource widely used by students, educators, and professionals alike. We are proud to offer a user-friendly platform that allows easy navigation and quick access to the test bank questions you need.
If you’re looking for a reliable resource to enhance your test preparation, our test bank is your go-to solution. Join thousands of satisfied users who have benefited from our comprehensive collection of test banks. Start practicing with our nursing test bank, pharmacology test bank, med surg test bank, NCLEX test bank, SAT bank, and more today to boost your confidence and increase your chances of success in any exam or test!

Reviews
There are no reviews yet.